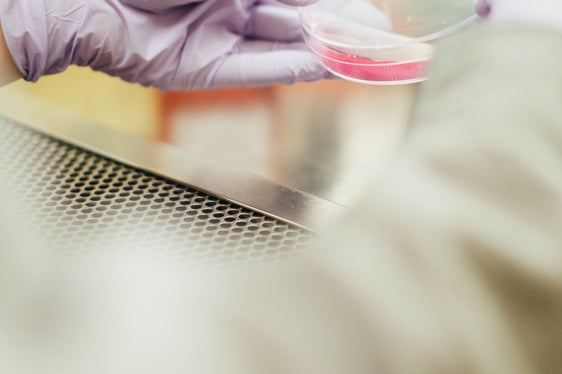
Wer in der Euregio innovative Produkte, Technologien oder Dienstleistungen im Bereich von Gesundheit und Biowissenschaft entwickelt hat, kann sich bis zum 31. Mai um den Innovationspreis bewerben. (Foto: Unsplash)

Euregio-Innovationspreis im Zeichen von Gesundheit und Life Sciences
Wer in der Euregio innovative Produkte, Technologien oder Dienstleistungen im Bereich von Gesundheit und Biowissenschaft entwickelt hat, kann sich bis zum 31. Mai um den Innovationspreis bewerben.

Die Europaregion Tirol-Südtirol-Trentino hat gemeinsam mit den Wirtschafts- und Handelskammern der Europaregion - nunmehr zum fünften Mal - den Euregio-Innovationspreis ausgeschrieben. In diesem Jahr steht das Thema "Gesundheit und Life Sciences" im Mittelpunkt. "Die große Bedeutung der Gesundheits- und Biowissenschaften wurde uns nicht zuletzt von der Corona-Pandemie vor Augen geführt", betont Landeshauptmann Arno Kompatscher, der in der Landesregierung derzeit neben der Forschung und Innovation auch die Gesundheitsagenden betreut. "Forschungsfortschritte in diesem Bereich erhöhen die Lebenserwartung und verbessern die Lebensqualität", betont Kompatscher. Der Landeshauptmann ruft Forschende und Unternehmen zur Beteiligung auf.
Bewerbungen bis zum 31. Mai
Unternehmen und Forschende können ihre innovativen Produkte, Technologien und Dienstleistungen im Bereich von Gesundheit und Biowissenschaften bis zum 31. Mai 2022 einreichen. Die Einreichung ist in den drei Kategorien Biotechnologie und Pharma, Lebensmitteltechnologie und gesunde Ernährung sowie Digital Health und Medizintechnik möglich. Teilnehmende sollten entweder aus der Europaregion stammen oder in einem Unternehmen, einer Universität, einer Hochschule oder einer Forschungseinrichtung der Euregio tätig sein. Die ersten drei Preise beinhalten ein gemeinsames Coaching der Standortagenturen im Wert von 5000 Euro pro Gewinner, zusätzlich wird ein Betrag von 5000 bis 1000 Euro als Preisgeld ausbezahlt.
Die Finalisten werden eingeladen, am 20. und 21. August bei den Tiroltagen des Europäischen Forums Alpbach ihre Einreichungen der hochkarätigen Jury unter dem Vorsitz von Josef Margreiter, Geschäftsführer der Lebensraum Tirol Holding GmbH, vorzustellen. Die Preisverleihung findet am 21. August statt.
Informationen:
www.euregio.info/innovation
jw
![[Externer Link] Webseite - Autonome Provinz Bozen - Südtirol](/css/img/APBZ_Logo_Website_DE_IT_LAD.svg)